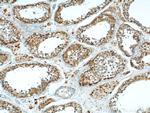
MRAP Antibody in Immunohistochemistry (Paraffin) (IHC (P))

Search
Proteintech
MRAP Polyclonal Antibody
{{$productOrderCtrl.translations['antibody.pdp.commerceCard.promotion.promotions']}}
{{$productOrderCtrl.translations['antibody.pdp.commerceCard.promotion.viewpromo']}}
{{$productOrderCtrl.translations['antibody.pdp.commerceCard.promotion.promocode']}}: {{promo.promoCode}} {{promo.promoTitle}} {{promo.promoDescription}}. {{$productOrderCtrl.translations['antibody.pdp.commerceCard.promotion.learnmore']}}
产品信息
19512-1-AP
种属反应
已发表种属
宿主/亚型
分类
类型
抗原
偶联物
形式
浓度
规格
纯化类型
保存液
内含物
保存条件
运输条件
产品详细信息
The antibody can recognize the isoform 1, isoform 2, and isoform 4.
靶标信息
MRAP encodes a melanocortin receptor-interacting protein. The encoded protein regulates trafficking and function of the melanocortin 2 receptor in the adrenal gland. The encoded protein can also modulate signaling of other melanocortin receptors. Mutations in this gene have been associated with familial glucocorticoid deficiency type 2.
仅用于科研。不用于诊断过程。未经明确授权不得转售。
生物信息学
蛋白别名: B27; Fat cell-specific low molecular weight protein; Fat tissue-specific low MW protein; Melanocortin-2 receptor accessory protein; membrane protein expressed in adipocytes; membrane protein; expressed in fat cells
基因别名: 1110025G12Rik; B27; C21orf61; FALP; FGD2; GCCD2; MRAP; MRAP1; ORF61
UniProt ID: (Human) Q8TCY5, (Mouse) Q9D159
Entrez Gene ID: (Human) 56246, (Mouse) 77037